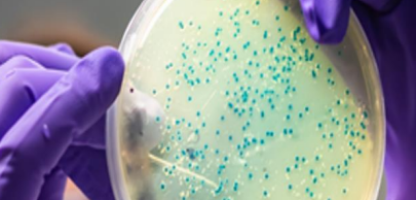
Signals Notebook for Molecular Biology

Signals Notebook™
The premier cloud-native ELN
Accelerate your research across Pharmaceuticals and Biotechnology, Chemicals and Materials, and Food, Flavor and Fragrance with the only cloud‑native ELN that seamlessly integrates ChemDraw™ and Spotfire®.

Trusted By Companies Worldwide
Equip your R&D teams for today’s scientific demands
The premier SaaS Electronic Laboratory Notebook used by 1 million scientists and powered by ChemDraw™.
Access your work anywhere with a cloud‑native architecture that delivers automatic updates and effortless scalability as your teams grow.
Automate stoichiometry calculations and streamline chemical search with native ChemDraw™ integration.
Collaborate in real time by sharing data, reviewing experiments, and making faster, data‑driven decisions.
Accelerate your research with a rapid release cycle that delivers 10 updates per year, adding new features, enhancements, and continuous improvements.

Simplicity down to a science.
Take control of your research data
Document experiments with flexible templates, rich text formatting, and embedded multimedia. Organize data with customizable folder structures, tags, and powerful search capabilities. Maintain complete traceability with automatic versioning and comprehensive audit trails for regulatory compliance.
Collaborate in real-time across teams
Share notebooks and experiments with granular permissions. Comment, review, and approve entries with electronic signatures. Get notified of updates and mentions. Work together seamlessly whether your team is in the lab, at home, or across the globe.
Integrate with your research ecosystem
Connect analytical instruments with Signals DLX for automated data capture. Manage chemical inventory directly within your notebook. Use open APIs to integrate with LIMS, ERP, and other enterprise systems. Build custom workflows that fit your unique research needs.
Expand the Power of Signals Notebook
Building on Signals Notebook’s foundation, Signals One adds AI-enhanced workflows, structured data handling, deeper SAR insights, and integrated analytics.
Security
SOC 2 Certified
Independently audited security controls ensure your sensitive research data meets the highest industry standards.
Secure Cloud Infrastructure
Enterprise-grade AWS infrastructure with encryption at rest and in transit protects your intellectual property.
Granular Access Control
Role-based permissions and multi-factor authentication ensure only authorized users access your sensitive research data.
Regulatory Compliance Ready
Built to support 21 CFR Part 11 requirements with electronic signatures, audit trails, and validation documentation.
Start your free trial
Experience Signals Notebook with full access to ChemDraw integration, collaboration tools, and cloud-native capabilities for your team.
Buy Signals Notebook now
Purchase Signals Notebook Standard Edition today and start capturing research data immediately.
Talk to our team
Schedule a consultation with our scientific solutions experts to discuss your specific research workflows, requirements, and implementation needs.
Enhance your R&D Workflows
Complete your R&D data workflow journey
ELN with Signals One, the comprehensive solution unifying Signals Notebook with advanced analytics and enterprise data management.
Eliminate manual instrument data entry forever
Stop copying instrument data by hand. Signals DLX automatically captures, parses, and organizes analytical data from your instruments directly into Signals Notebook.

Manage chemicals and samples
Integrated inventory management
- Track chemicals, reagents, and samples directly within your notebook no switching systems.
- Scan barcodes to capture materials quickly and accurately.
- Locate inventory instantly with built‑in location tracking and complete material traceability.
- Stay ahead of supply shortages with automatic low‑stock alerts.
Deploy with confidence in regulated environments
Validation support and documentation
- Accelerate your Signals Notebook validation with comprehensive documentation packages and qualification protocols.
- Use prebuilt IQ, OQ, and PQ templates designed specifically for regulated pharmaceutical and biotech environments.
- Leverage expert validation support to streamline deployment and reduce compliance effort.

Signals Notebook Solutions Versus Other Offerings
The difference between cloud-hosted and truly cloud-native
Resources
Keep up with the latest with guides, research, and insights.
Signals Notebook FAQs
Ready to transform your lab with Signals Notebook?
Start your free trial
Experience Signals Notebook with full access to ChemDraw integration, collaboration tools, and cloud-native capabilities for your team.
Buy Signals Notebook now
Purchase Signals Notebook Standard Edition today and start capturing research data immediately.
Talk to our team
Schedule a consultation with our scientific solutions experts to discuss your specific research workflows, requirements, and implementation needs.